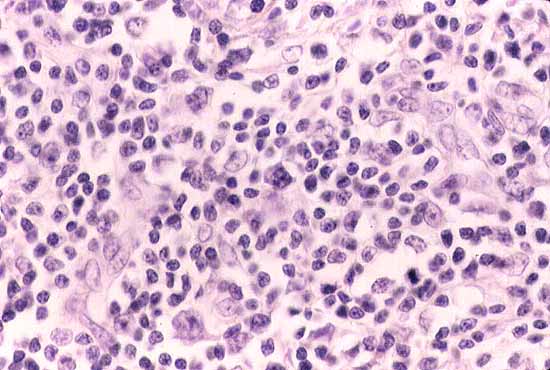
fig. 3
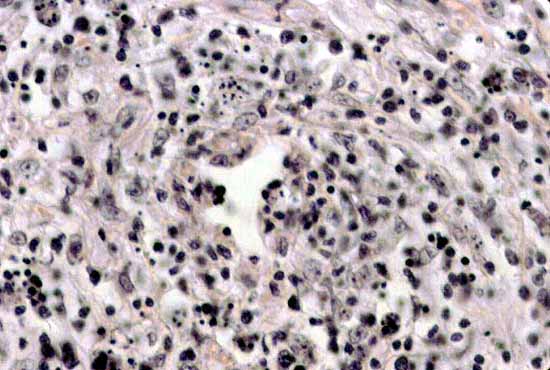
fig. 4

LINFOMA DE CELULAS T DEL PANICULO SUBCUTANEO.
Tudela Pallares, J.; *Evole Buselli, M.; **Jarque Ramos, I.; Hernández Martí, M.

ICONOGRAFÍA
 |
|
Figura 1 |
 |
|
Figura 2 |
|
|
Figura 3 |
|
|
Figura 4 |
 |
|
Figura 5 |
Tudela Pallares, J.; *Evole Buselli, M.; **Jarque Ramos, I.; Hernández Martí, M.
Copyright © 1998. Reservados todos los derechos.